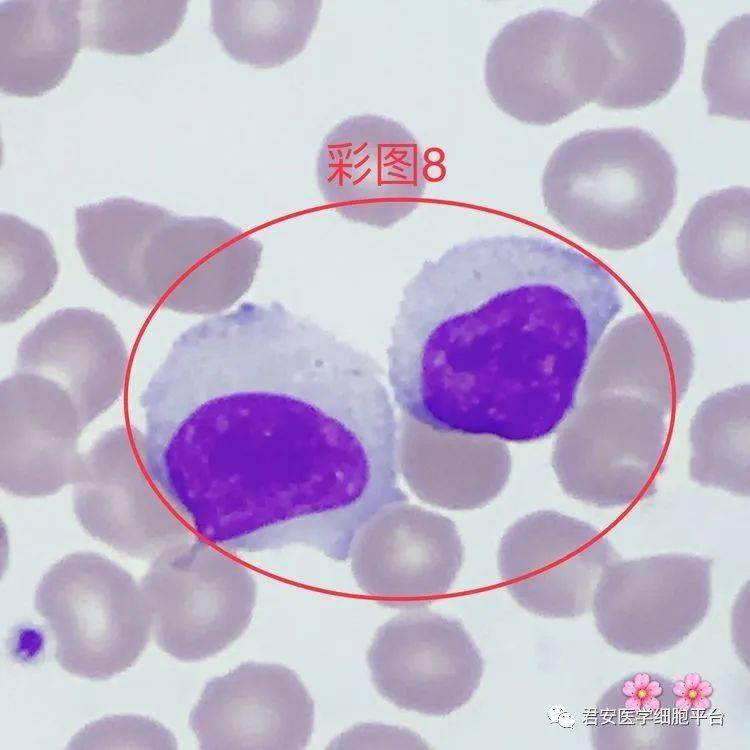
固缩成紫红色或紫黑色,副染色质不明显,胞质内见2个豪焦氏小体

豪焦小体

嗜多色性红细胞内一个豪焦小体,多见于溶贫,巨幼贫和mds.
图片尺寸1280x1033
点击下方空白区域查看答案▼「含有豪焦氏小体的嗜多色性红细胞」形态
图片尺寸750x750
学培训答案——城口县检验质控心承办2 答 案:有核红细胞内豪焦小体
图片尺寸990x740
实验诊断学彩色图谱_知网百科
图片尺寸890x663
各位老师好,本人工作经验不足,碰到一标本cbc除血小板极低外, 其他
图片尺寸800x600
各位老师好,本人工作经验不足,碰到一标本cbc除血小板极低外, 其他
图片尺寸800x600
细胞中的这个小物体连检验科医生都会错过
图片尺寸799x1730
「血字研究」第二弹~|一页手册·协和八
图片尺寸196x227
09形态特征:胞体不规则形;胞质丰富,呈淡蓝色,含有较多,大小不一的
图片尺寸750x750
明显且较透明,无核仁,胞质多淡红色,胞质内含有1个暗紫红色的圆形小体
图片尺寸750x599
yoyo781206 11-08 13:44 h-j小体是核的残留物,表现为在成熟或晚幼红
图片尺寸251x230
【讨论】发几个图片大家一起看
图片尺寸640x853
豪焦小体
图片尺寸504x331
固缩成紫红色或紫黑色,副染色质不明显,胞质内见2个豪焦氏小体
图片尺寸750x750
学培训答案——城口县检验质控心承办2 答 案:有核红细胞内豪焦小体
图片尺寸988x749
油镜下观察,胞浆内紫色小点,是染料附着.
图片尺寸800x600
肾小体
图片尺寸1080x810
其它 2018年细胞形态学培训考试 a:豪焦小体 b: rusell小体 c:杜勒小
图片尺寸596x453
其他红细胞上的紫色小点,是染料附着.
图片尺寸800x600
其它 2018年细胞形态学培训考试 a:疟原虫环状体 b: 卡波环 c: 豪周小
图片尺寸596x454